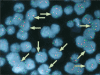
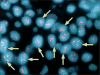

Breast cancer and aneusomy 17: implications for carcinogenesis and therapeutic response
- PMID: 19261255
- PMCID: PMC5549275
- DOI: 10.1016/S1470-2045(09)70063-4
Breast cancer and aneusomy 17: implications for carcinogenesis and therapeutic response
Abstract
Abnormalities of chromosome 17, recognised over two decades ago to be important in tumorigenesis, often occur in breast cancer. Changes of specific loci on chromosome 17 including ERBB2 amplification, P53 loss, BRCA1 loss, and TOP2A amplification or deletion are known to have important roles in breast-cancer pathophysiology. Numerical aberrations of chromosome 17 are linked to breast-cancer initiation and progression, and possibly to treatment response. However, the clinical importance of chromosome 17 anomalies, in particular the effect on ERBB2 protein expression, is unknown. Reports are conflicting regarding the association of copy gain of chromosome 17 (polysomy 17) with strong ERBB2 protein expression in the absence of true ERBB2 gene amplification. Copy-number anomalies in chromosome 17 seem to be common in tumours that show discrepant ERBB2 expression and in tumours with discordant ERBB2-protein and ERBB2 gene copy number measurements. The mechanisms of ERBB2 dosage changes-gene amplification versus chromosome gain and loss-probably differ in primary and metastatic disease; however, a correction for chromosome 17 copy-number is necessary to completely distinguish between these mechanisms. A better understanding of how polysomy 17 affects gene-copy number and protein expression will help to select patients who will respond to therapies targeting ERBB2 and other protein products of chromosome 17 loci.
Figures

References
-
- Boveri T. On multipolar mitosis as a means of analysis of the cell nucleus. Develop Biol. 1902;35:67–90.
-
- Geleick D, Muller H, Matter A, Torhorst J, Regenass U. Cytogenetics of breast cancer. Cancer Genet Cytogenet. 1990;46:217–29. - PubMed
-
- Thompson F, Emerson J, Dalton W, et al. Clonal chromosome abnormalities in human breast carcinomas. I. Twenty-eight cases with primary disease. Genes Chromosomes Cancer. 1993;7:185–93. - PubMed
-
- Chin K, DeVries S, Fridlyand J, et al. Genomic and transcriptional aberrations linked to breast cancer pathophysiologies. Cancer Cell. 2006;10:529–41. - PubMed
-
- Yao J, Weremowicz S, Feng B, et al. Combined cDNA array comparative genomic hybridization and serial analysis of gene expression analysis of breast tumor progression. Cancer Res. 2006;66:4065–78. - PubMed
Publication types
MeSH terms
Substances
Grants and funding
LinkOut - more resources
Full Text Sources
Medical
Research Materials
Miscellaneous